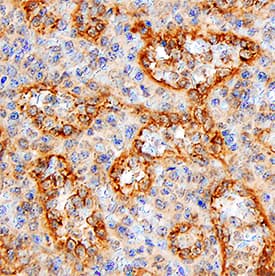
HVEM/TNFRSF14 antibody in Human Spleen by Immunohistochemistry (IHC-P).

Human HVEM/TNFRSF14 Antibody
R&D Systems, part of Bio-Techne | Catalog # AF356


Key Product Details
Species Reactivity
Validated:
Cited:
Applications
Validated:
Cited:
Label
Antibody Source
Product Specifications
Immunogen
Pro37-Val202
Accession # Q92956
Specificity
Clonality
Host
Isotype
Scientific Data Images for Human HVEM/TNFRSF14 Antibody
Detection of Human HVEM/TNFRSF14 by Western Blot.
Western blot shows lysates of human thymus tissue and human peripheral blood mononuclear cells (PBMCs). PVDF membrane was probed with 1 µg/mL of Goat Anti-Human HVEM/TNFRSF14 Antigen Affinity-purified Polyclonal Antibody (Catalog # AF356) followed by HRP-conjugated Anti-Goat IgG Secondary Antibody (HAF017). A specific band was detected for HVEM/TNFRSF14 at approximately 40 kDa (as indicated). This experiment was conducted under reducing conditions and using Immunoblot Buffer Group 1.HVEM/TNFRSF14 in Human Spleen.
HVEM/TNFRSF14 was detected in immersion fixed paraffin-embedded sections of human spleen using Goat Anti-Human HVEM/TNFRSF14 Antigen Affinity-purified Polyclonal Antibody (Catalog # AF356) at 10 µg/mL for 1 hour at room temperature followed by incubation with the Anti-Goat IgG VisUCyte™ HRP Polymer Antibody (VC004). Tissue was stained using DAB (brown) and counterstained with hematoxylin (blue). Specific staining was localized to cell surfaces. View our protocol for IHC Staining with VisUCyte HRP Polymer Detection Reagents.Detection of Human HVEM/TNFRSF14 by Block/Neutralize
Differential inhibition of HVEM/CD160 binding with benchmark tool antibodies. TRF assay measuring the potency of different antibodies to inhibit the binding of recombinant human HVEM-Fc chimera to CD160+ CHO-K1 cells. A) CD160 monoclonal antibodies inhibit binding of HVEM-Fc to both CD160-GPI and CD160-TM isoforms. B) Polyclonal HVEM (left panel) and monoclonal HVEM (right panel) antibodies both enhance binding of HVEM-Fc to CD160-TM isoform. The polyclonal anti-HVEM inhibits HVEM-Fc binding to CD160-GPI (left panel). Antibody concentrations are plotted on the X axis whereas, the calculated percentage of inhibition of binding is plotted on the Y axis. Matched isotype control antibody for each individual antibody candidate was also used in the assay (empty circles and squares). CTL = control, mAb = monoclonal antibody, pAb = polyclonal antibody. Image collected and cropped by CiteAb from the following open publication (https://pubmed.ncbi.nlm.nih.gov/25179432), licensed under a CC-BY license. Not internally tested by R&D Systems.Applications for Human HVEM/TNFRSF14 Antibody
Immunohistochemistry
Sample: Immersion fixed paraffin-embedded sections of human spleen
Western Blot
Sample: Human thymus tissue and human peripheral blood mononuclear cells (PBMCs)
Formulation, Preparation, and Storage
Purification
Reconstitution
Formulation
Shipping
Stability & Storage
- 12 months from date of receipt, -20 to -70 °C as supplied.
- 1 month, 2 to 8 °C under sterile conditions after reconstitution.
- 6 months, -20 to -70 °C under sterile conditions after reconstitution.
Background: HVEM/TNFRSF14
Herpesvirus entry mediator (HVEM), also referred to as TR2 (TNF receptor-like molecule) and ATAR (another TRAF-associated receptor), is a type I membrane protein belonging to the TNF/NGF receptor superfamily. In the TNF superfamily nomenclature, HVEM is referred to as TNFRSF14. Human HVEM cDNA encodes a 283 amino acid (aa) residue protein with a probable 36 aa residue signal peptide, a 166 aa residue extracellular domain, a 23 aa residue transmembrane region and a 58 aa residue cytoplasmic region. The extracellular domain of HVEM contains several cysteine-rich repeats characteristic of TNF receptor superfamily members. The short cytoplasmic region lacks a death domain present in some TNF receptor family members, but contains a TRAF (TNF receptor-associated factor) interaction domain. HVEM expression has been detected in peripheral blood T cells, B cells, monocytes and in various tissues enriched in lymphoid cells. The extracellular domain of HVEM has been shown to interact directly with the herpes simplex virus envelope glycoprotein D. Two TNF superfamily ligands, including the secreted TNF‑ beta (lymphotoxin alpha) and the membrane protein LIGHT (lymphotoxins, exhibits inducible expression, and competes with HSV glycoprotein D for HVEM, a receptor expressed by T lymphocytes), have been shown to be the cellular ligands for HVEM. Besides HVEM, LIGHT can also interact with LT betaR, the receptor for lymphotoxin alpha beta heterotrimer. The role of the HVEM-LIGHT/LT beta receptor-ligand pair in immune function and herpesvirus pathobiology remains to be elucidated.
References
- Hsu, H. et al. (1997) J. Biol. Chem. 272:13471.
- Mauri, D.N. et al. (1998) Immunity 8:21.
- Montgomery, R.I. et al. (1996) Cell 87:427.
Long Name
Alternate Names
Gene Symbol
UniProt
Additional HVEM/TNFRSF14 Products
Product Documents for Human HVEM/TNFRSF14 Antibody
Product Specific Notices for Human HVEM/TNFRSF14 Antibody
For research use only